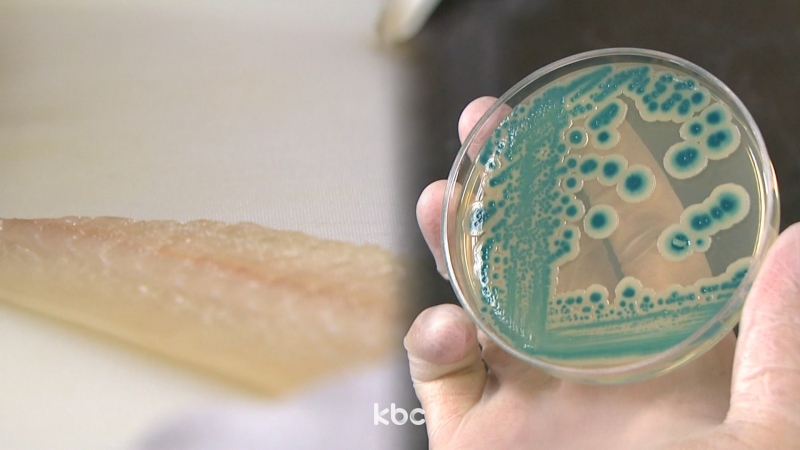

전라북도 군산시는 군산 옥도면의 한 민박집 이용객 16명이 식중독 의심 증세를 보여 역학조사를 하고 있다고 밝혔습니다.
이들은 지난 1일 점심과 저녁 식사로 꽃게탕, 회 등을 먹은 뒤 복통, 설사, 구토 등의 식중독 의심증세를 보였으며 모두 병원 치료를 받은 뒤 귀가했습니다.
군산시는 이날 총 24명이 함께 식사했으며 나머지 8명은 아직 특별한 증상이 없는 것으로 알려졌습니다.
군산시보건소는 환자들과 조리 종사자, 조리 기구 등에서 검체를 채취해 전북도 보건환경연구원에 정밀 검사를 의뢰했습니다.
댓글
(0)